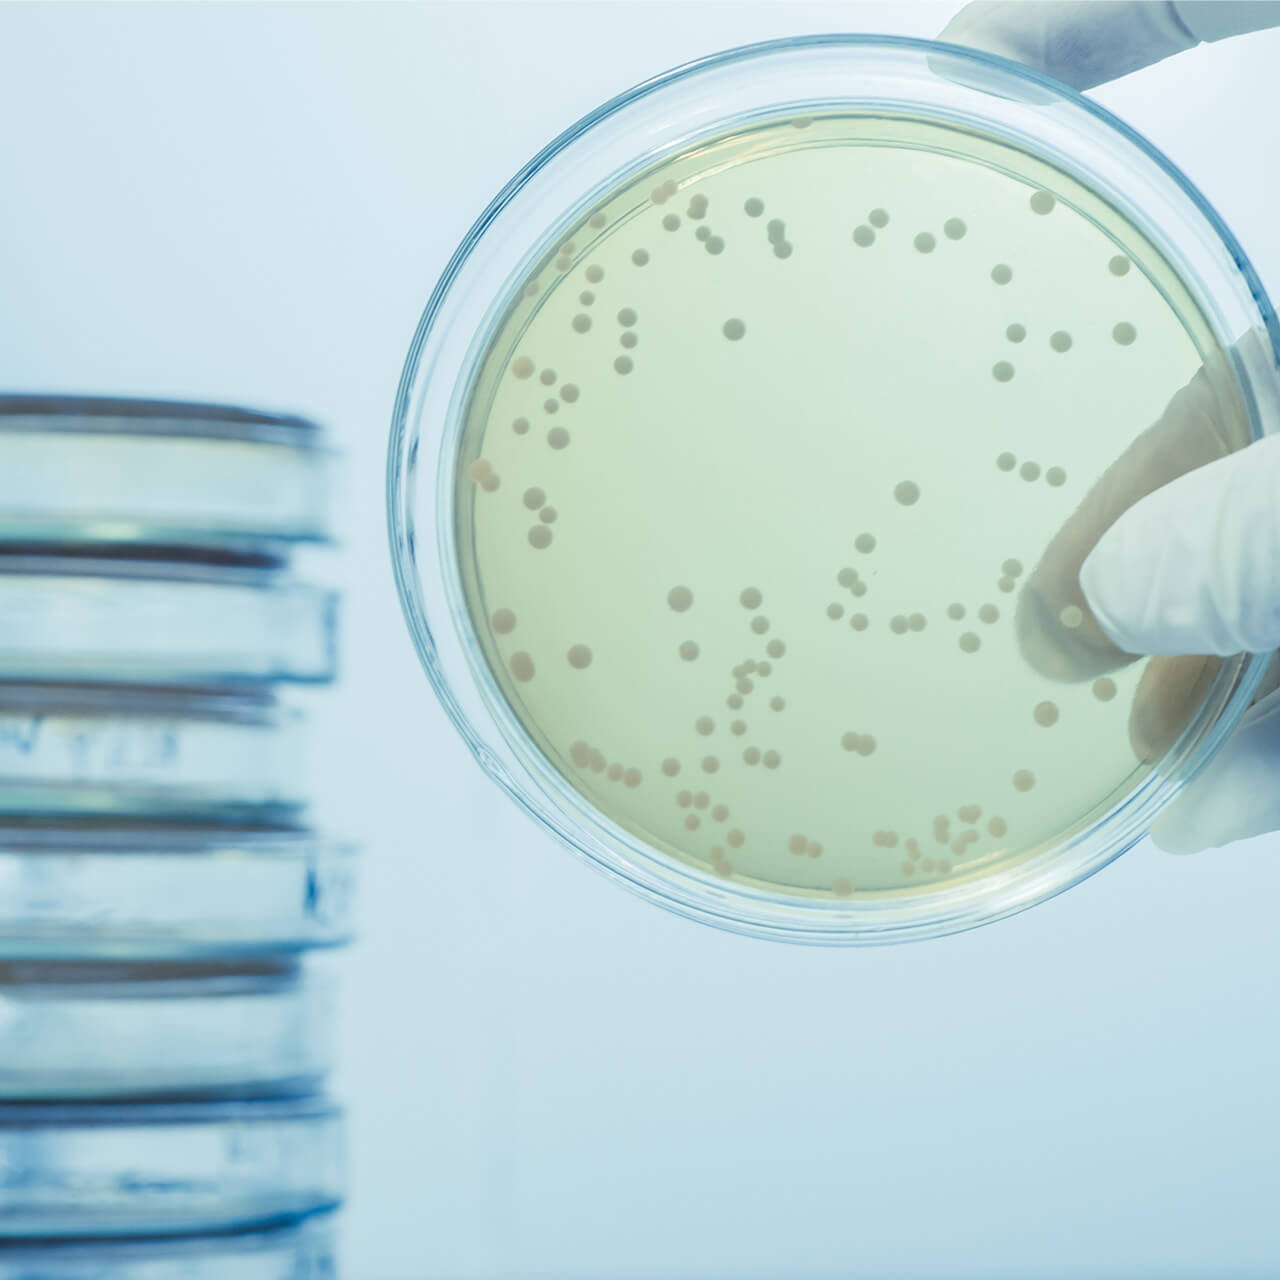
microbiological monitoring

What you need to know about Pharmaceutical water systems
ccs
And BWT solutions regarding your Contamination Control Strategy.
With the release of the EU GMP Annex 1 in August 2022, an implementation of a Contamination Control Strategy (CCS) has become mandatory. The scope of the CCS has changed as well. It includes not only the testing of final product, for the release relevant parameters such as conductivity, TOC and bioburden, but also the monitoring of the overall process. Based on a contamination risk management (CRM), measures and activities must be implemented to guarantee the specified functionalities of each individual process step of the water purification system, in particular cold water systems.


With BWT solutions, you are prepared for the implementation of a CCS.
We are here to assist you.
CCS: a holistic concept


The CCS can be broken down to four elements
Contamination Risk Management
The foundation of a successful Contamination Control Strategy is a Contamination Risk Management (CRM) which requires a deep understanding of the individual process steps and their contribution to the contamination risk. Based on the CRM, which is required to identify all risks in your water system, a CCS can be implemented.The four main elements of CCS
Prevent
The prevention of a microbial contamination is crucial within the water generation for the pharmaceutical industry. But how can we persistently prevent such? By understanding the process and thus being able to estimate the contribution of the risk for a microbial contamination for each individual process step.
The design of the plant and the maintenance procedures are the two crucial aspects. We need to understand where the germs come from, therefore it is crucial to know how the entire water generation process is structured.

Control
Heterotrophic Plate Count (HPC) is the only compendial method for microbial contamination monitoring today. A serious concern for implementing a CCS as described in Annex I, is the fact that HPC does not detect all microorganisms in a sample. Only colony forming units (CFU) are visible.
Studies have shown that the number of CFU does not reflect the number of microorganisms in a system. To grasp the real microbial situation in a water purification system, rapid methods have to be considered to gain more control.
Combat
There is no PW or WFI water generation and distribution system that is sterile over the whole lifecycle. Microorganisms always find a way into the plant. Either through the raw water, back contamination through user points or during maintenance activities. Sterility is technically hard to achieve and would generate a high effort and cost and the sterilization procedures exert enormous stress to the equipment.




Document
A key success factor for a CCS is a gapless documentation. Just talking about 21 CFR Part 11 or audit trail is not sufficient anymore. It’s more about data generated during the system lifecycle, raw data, meta data et cetera. Due to the increasing demands in data management and data integrity e.g., ALCOA or ALCOA+ principle and other regulations, the effort for compliant documentation is permanently increasing. A serious number of concerns and warning letters from the FDA are related to data integrity violations.
Events
See you soon!








